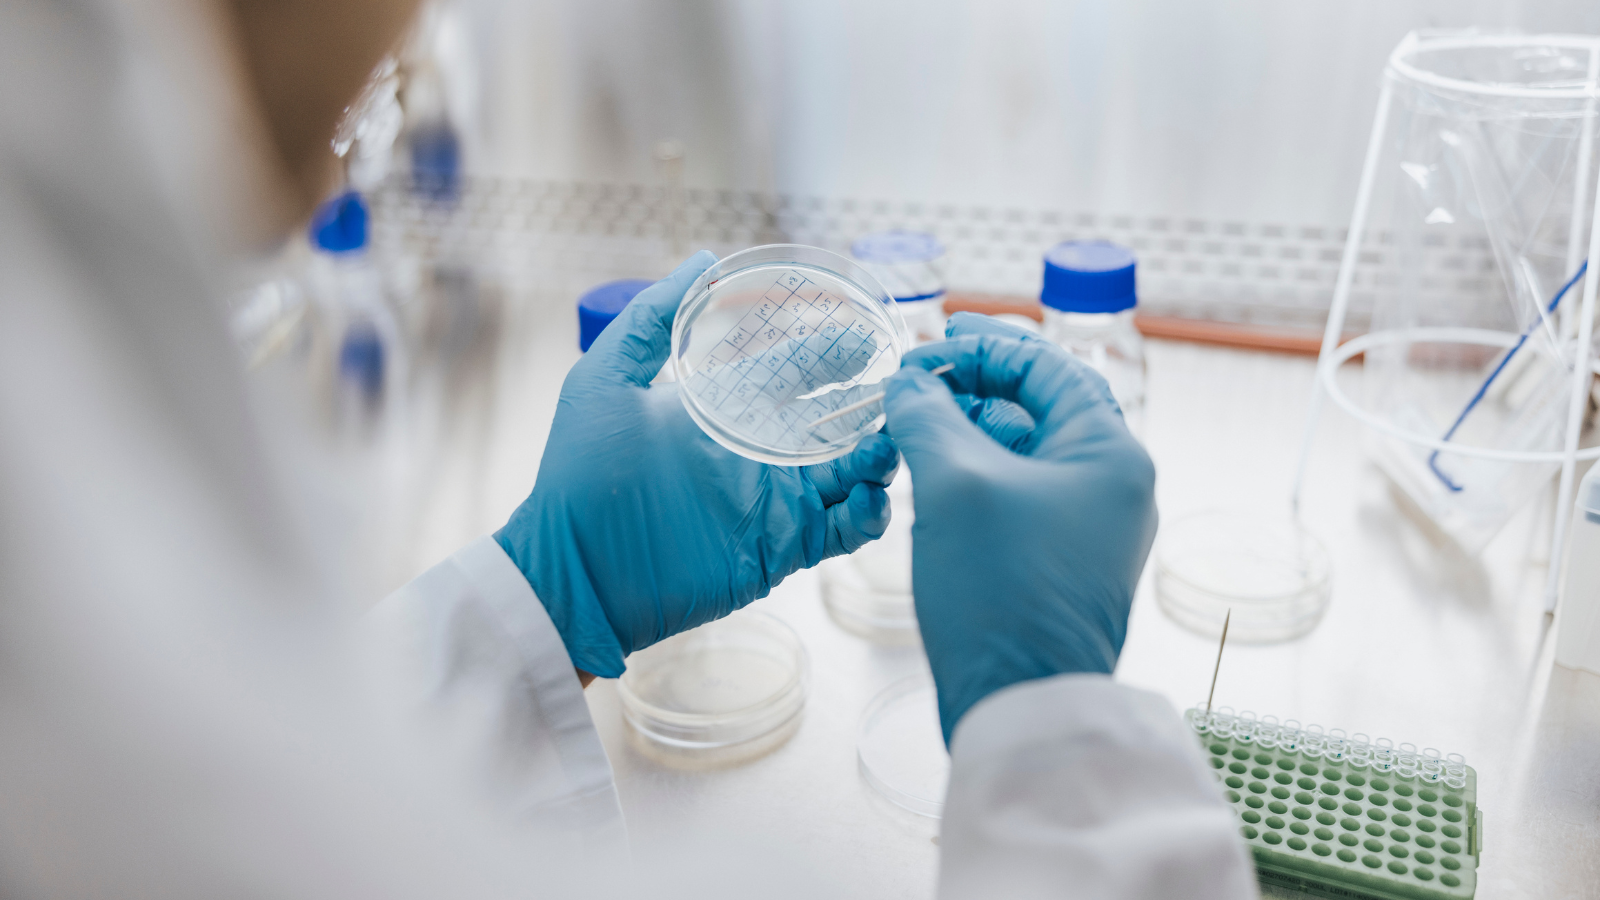

Our Guide to Mastering Lab Standard Operating Procedures
Learn how to optimize laboratory operations with Standard Operating Procedures. Discover the benefits of digital lab SOPs and best practices for implementation.
Download Whitepaper
Within modern, fast-paced laboratory settings, maintaining consistency, accuracy, and efficiency is crucial to achieving reliable results and ensuring safety. This is where Standard Operating Procedures (SOPs) come into play. SOPs are the backbone of any well-run laboratory, providing a structured framework that ensures all processes are performed uniformly and to the highest standards. They serve not only as a guideline for best practices but also as a critical resource for training new staff and maintaining compliance with regulatory requirements.
In this blog, we will highlight:
- What are lab standard operating procedures?
- The benefits of implementing robust lab SOPs
- Digital SOPs: transforming lab procedures
- Best practices for implementing SOPs in your lab
Read on as we delve into the world of lab SOPs, explore their far-reaching benefits, and highlight how digital solutions are transforming SOP management. They make it easier to create, update, and disseminate procedures across teams. Digital lab SOPs not only streamline lab operations but also ensure that all personnel have access to the most up-to-date information, leading to improved laboratory performance and research outcomes.
What are lab standard operating procedures?
Lab SOPs are detailed, validated step-by-step instructions designed to achieve uniformity in performing specific laboratory procedures. They play a crucial role in ensuring consistency, accuracy, and safety in lab operations, and also play a role in ensuring regulatory compliance in the lab. SOPs differ from lab protocols, although both are essential. While lab protocols describe the general principles and guidelines of lab practices, SOPs are often validated to a higher level of scrutiny, and provide step-by-step instructions for specific tasks.
Common types of SOPs in labs include procedures for sample handling, equipment usage, safety protocols and quality control measures. By adhering to SOPs, labs can minimise errors, enhance reproducibility and comply with regulatory standards. Well written SOPs also facilitate smooth training of new personnel, ensuring they can quickly and accurately perform their duties.
The benefits of implementing robust lab SOPs
Implementing robust SOPs in your lab is essential for achieving consistent, reliable, and compliant operations. Lab SOPs provide a structured framework for performing tasks uniformly, ensuring that every team member follows the same steps and standards. By clearly defining procedures, SOPs help minimize errors, streamline workflows, and maintain high-quality results.
Here are some of the key benefits of implementing SOPs in your laboratory:
Enhanced consistency and reliability
Lab SOPs ensure that all lab activities are performed uniformly, which is essential for achieving consistent and reliable research outcomes. By following standardized procedures, laboratories can reduce variability and ensure that results are reproducible.
- Ensures all lab activities are performed uniformly.
- Reduces variability and enhances the reproducibility of results.
- Provides clear guidelines for conducting experiments and procedures.
Improved compliance and traceability
Robust SOPs help labs comply with regulatory requirements and standards by providing detailed documentation of procedures. This traceability is crucial for regulatory audits and inspections, making it easier to track and verify lab activities.
- Helps comply with regulatory requirements and standards.
- Facilitates easier tracking and verification of lab activities.
- Provides detailed documentation for audits and inspections.
Increased efficiency
By streamlining workflows and reducing the time spent on repetitive tasks, SOPs enhance lab efficiency. They optimise lab operations and resource management, allowing researchers to focus on more critical activities.
- Streamlines workflows and reduces time spent on repetitive tasks.
- Optimises lab operations and resource management.
- Allows researchers to focus on more critical and innovative activities.
Better training and onboarding
SOPs serve as comprehensive training tools for new staff, ensuring proper training and adherence to lab procedures. They provide clear, detailed instructions that help new employees quickly get up to speed.
- Serves as a comprehensive training tool for new staff.
- Ensures proper training and adherence to lab procedures.
- Provides clear, detailed instructions for quick onboarding.
By implementing robust SOPs, laboratories can improve their operational efficiency and reliability, ensure compliance with regulatory standards, and enhance the overall quality of their research. SOPs are a critical component in maintaining a disciplined and efficient laboratory environment.
Digital SOPs: transforming lab procedures
In the modern laboratory, the shift from traditional paper-based SOPs to digital SOPs is revolutionising how lab procedures are conducted. Digital lab SOPs offer a multitude of advantages that go beyond the capabilities of their paper counterparts, providing labs with enhanced accessibility, real-time updates, and improved collaboration.
By leveraging digital solutions, laboratories can ensure that their procedures are always current, easily accessible, and securely stored. This transformation not only streamlines lab operations but also significantly reduces the risk of human error and enhances overall efficiency. Let’s explore the key benefits and features of digital SOPs and how they can elevate your lab management to the next level.
- Quick and easy access from any device
- Real-time updates and version control
- Improved collaboration and sharing capabilities
- Enhanced searchability and organization
- Robust security measures
SciSure for digital lab SOP management
SciSure for Research (formerly eLabNext) is a digital lab platform with comprehensive features for digital SOP management, streamlining the creation, storage, and sharing of standard operating procedures. This innovative platform ensures that all protocols are easily accessible and up-to-date, enhancing collaboration and compliance across teams. With user-friendly features and robust security measures, SciSure empowers organizations to maintain high standards of quality and efficiency in their operations.
Some of the key features include:
- Dynamic SOP creation with customizable templates and AI generation features that allow users to tailor documents to their specific needs and ensure consistency across all procedures.
- Real-time updates and version control enable teams to collaborate seamlessly, track changes, and maintain an accurate history of document revisions.
- A centralized repository for easy access and management, ensuring that all standard operating procedures are organized and readily available to all team members whenever needed.
- Integrates seamlessly with SciSure’s ELN and LIMS capabilities for comprehensive lab management, simplifying the workflow by connecting SOPs directly with lab data and enhancing overall efficiency in research and development processes.
With SciSure, labs can create, manage, and update their lab SOPs more efficiently than ever before. The platform allows for easy assignment of variable parameters, making it simple to customize procedures as needed. Plus, the ability to globally share lab protocols facilitates collaboration and standardization across different lab groups or organizations.
Best practices for implementing SOPs in your lab
As we have highlighted, implementing robust SOPs in your laboratory is critical for maintaining consistency, ensuring compliance, and boosting overall efficiency. However, the process of creating and integrating SOPs into your workflow can sometimes be challenging. Here's our top tips for successfully implementing SOPs in your lab.
1. Assess current lab SOPs and identify gaps
Begin by conducting a comprehensive review of your existing Standard Operating Procedures (SOPs) to understand their current effectiveness and relevance. Identify specific areas that require improvement or standardization. This gap analysis will not only highlight inconsistencies and inefficiencies but also assist you in prioritizing which SOPs should be developed or updated first. By focusing on the most critical areas for enhancement, you can ensure that the revamped SOPs will have the greatest positive impact on your operations.
2. Involve your team in SOP development
Engage your lab staff in the creation and revision of SOPs. They're the ones who use these procedures daily, so their input is invaluable. Consider holding collaborative workshops where team members can contribute their expertise and insights.
3. Ensure SOPs are both clear and detailed
Write your SOPs in a clear, concise, and detailed manner. Include:
- Step-by-step instructions
- Safety precautions
- Troubleshooting tips
- Required materials and equipment
Use simple language and avoid jargon where possible. Include diagrams or images if they help clarify the procedures.
4. Regularly review and update SOPs
Schedule regular reviews of your SOPs to ensure they remain current and relevant. Update them to reflect:
- New equipment or techniques
- Changes in regulations or industry standards
- Improvements in processes based on experience
Consider setting up an annual review schedule for all SOPs, with more frequent reviews for critical or frequently used procedures.
5. Leverage digital solutions for SOP management
Utiliize digital tools like SciSure to manage and update your SOPs. These solutions offer:
- Easy creation and editing of SOPs
- Version control and change tracking
- Quick access and searchability
- Integration with other lab management systems
The blueprint for operational excellence
Lab SOPs are essential for maintaining consistency, efficiency, and compliance in laboratory settings. By implementing well-designed SOPs and leveraging digital solutions like SciSure, labs can significantly enhance their operations, improve research outcomes, and stay ahead in today's competitive scientific landscape.
Read more of our blogs about modern lab management
Discover the latest in lab operations, from sample management to AI innovations, designed to enhance efficiency and drive scientific breakthroughs.


